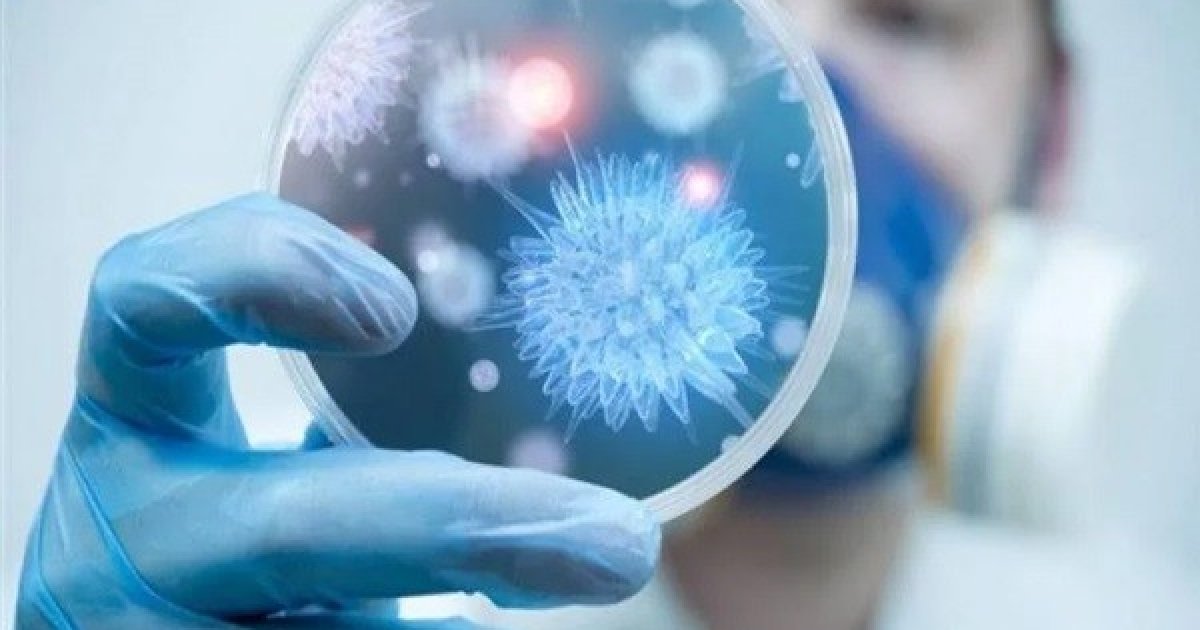

يجري مركز "غاماليا" الروسي حاليا التجارب ما قبل السريرية على لقاح ثوري للسرطان.
وقال رئيس المركز، ألكسندر غينتسبورغ، في تصريحات صحفية: "لقاحنا للسرطان علاجي، ومخصص للأشخاص الذين يعانون بالفعل من السرطان"، لافتا إلى أن "هذا الدواء يحمل اسم اللقاح لأنه مصمم لتنشيط جهاز المناعة المريض".
هذا العلاج سيمكن الخلايا الليمفاوية من العمل والتعرف على الخلايا السرطانية وتدمرها.
وأوضح أنه سيتم إنتاج لقاح فردي لكل مريض، ولكن باستخدام نفس التكنولوجيا، مضيفا: "سيأخذ الأطباء عينات من الأورام ومن الخلايا السليمة، وسيقوم الباحثون بمقارنتها وتحديد الأجزاء التي حدثت فيها الطفرة، وهذه الأجزاء بالتحديد ستصبح الأساس للقاح، وبمجرد دخولها إلى الجسم ستجذب انتباه الخلايا الليمفاوية التي ستدمر الخلايا المحقونة، وتتذكرها وتبدأ في محاربة الخلايا السرطانية".
وتابع: "طبقت هذه الآلية على الحيوانات المخبرية بنجاح، وهذا يدل على أن هذه الطريقة واعدة".